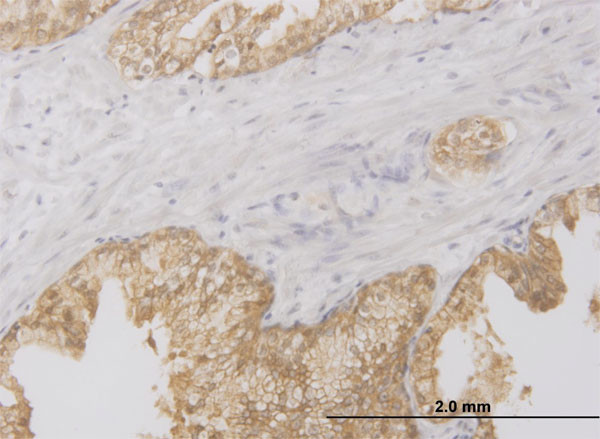
RIPK2 Antibody in Immunohistochemistry (Paraffin) (IHC (P))

Search
Abnova
RIPK2 Monoclonal Antibody (3D9)
{{$productOrderCtrl.translations['antibody.pdp.commerceCard.promotion.promotions']}}
{{$productOrderCtrl.translations['antibody.pdp.commerceCard.promotion.viewpromo']}}
{{$productOrderCtrl.translations['antibody.pdp.commerceCard.promotion.promocode']}}: {{promo.promoCode}} {{promo.promoTitle}} {{promo.promoDescription}}. {{$productOrderCtrl.translations['antibody.pdp.commerceCard.promotion.learnmore']}}






Please note: We are reviewing Western blot images included in the antibody testing data in our catalog, including those provided by third parties. Unless expressly labeled or annotated as “raw-unedited”, Western blot images included in the antibody testing data in our catalog may have been edited, optimized or otherwise adjusted for presentation.
产品信息
H00008767-M03
种属反应
宿主/亚型
分类
类型
克隆号
抗原
偶联物
形式
浓度
规格
纯化类型
保存液
内含物
保存条件
运输条件
产品详细信息
Sequence of this protein is as follows: LQPGIAQQWI QSKREDIVNQ MTEACLNQSL DALLSRDLIM KEDYELVSTK PTRTSKVRQL LDTTDIQGEE FAKVIVQKLK DNKQMGLQPY PEILVVSRSP SLNLLQNKSM
靶标信息
RIPK2 is a serine/threonine kinase that is involved in cell activation, proliferation, differentiation, and apoptosis. Upon stimulation by bacterial peptidoglycans, NOD1 and NOD2 are activated, oligomerize and recruit RIPK2 through CARD-CARD domains. Contributes to the tyrosine phosphorylation of the guanine exchange factor ARHGEF2 through Src tyrosine kinase leading to NF-kappaB activation by NOD2. Once recruited, RIPK2 autophosphorylates and undergoes 'Lys-63'-linked polyubiquitination by E3 ubiquitin ligases XIAP, BIRC2 and BIRC3. The polyubiquitinated protein mediates the recruitment of MAP3K7/TAK1 to IKBKG/NEMO and induces 'Lys-63'-linked polyubiquitination of IKBKG/NEMO and subsequent activation of IKBKB/IKKB. In turn, NF-kappa-B is released from NF-kappa-B inhibitors and translocates into the nucleus where it activates the transcription of hundreds of genes involved in immune response, growth control, or protection against apoptosis. Plays also a role during engagement of the T-cell receptor (TCR) in promoting BCL10 phosphorylation and subsequent NF-kappa-B activation.
仅用于科研。不用于诊断过程。未经明确授权不得转售。
篇参考文献 (0)
生物信息学
蛋白别名: CARD-containing IL-1 beta ICE-kinase; CARD-containing interleukin-1 beta-converting enzyme-associated kinase; EC 2.7.11.1; growth-in; kinase RIPK2; receptor (TNFRSF)-interacting serine-threonine kinase 2; Receptor-interacting protein 2; Receptor-interacting serine/threonine-protein kinase 2; RIP 2; RIP-2; RIP-like; RIP-like-interacting CLARP kinase; Tyrosine-protein kinase RIPK2; WUGSC:H_RG437L15.1
基因别名: 2210420D18Rik; CARD3; CARDIAK; CCK; D4Bwg0615e; RICK; RIP2; RIPK2; UNQ277/PRO314/PRO34092
UniProt ID: (Mouse) P58801
Entrez Gene ID: (Rat) 362491, (Mouse) 192656